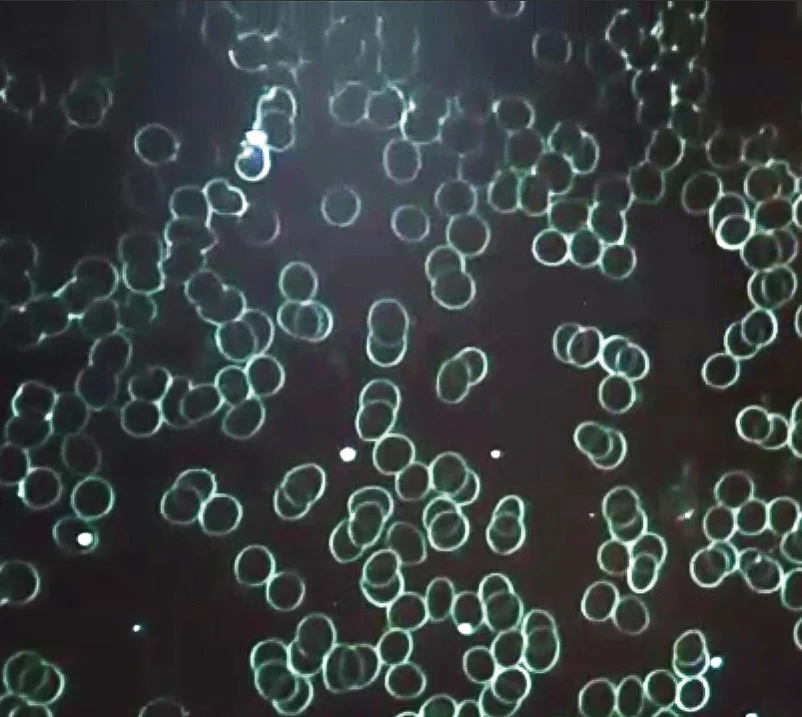

Sejtmasszázs
Himalájai Hangtálmasszázs®, avagy teljes sejtmasszázs

A Himalájai Hangtálmasszázs® olyan egészségjavító, lazító, teljesértékű masszázs módszer amely javítja az ember életét, egészségét és környezetét is jobbá, boldogabbá, harmonikusabbá, békésebbé és vidámabbá teszi. Segít a test energiaáramlásának javításában, így hozzájárulva az általános vitalitás és életerő fokozásához. Nyugtató hatású, segíti a pihenést, csökkenti a stresszt, szorongást és a feszültséget.
A tibeti gyógyításban a hangot régóta használják, mint terápiás eszközt. A hangok rezgései átmasszírozzák egész testünket, sejtszinten képes harmonizálni minket, megnyugtatni a teljes testet, csökkentve a stresszt, szorongást, feszültséget. Mivel az emberi test mintegy háromnegyede vízből áll, a Himalájai Hangtálmasszázs®, fizikai hatást gyakorol egész testünkre: a víz a hanghullámokat kiválóan továbbítja, a rezgések pedig eljutnak minden egyes sejtünkhöz, így minden egyes sejt külön-külön „sejtmasszázst” kap.

Dr. Ketskés Norbert A Hangrezgések hatása sejtjeinkre "TV2"

Az itt látható vizsgálati eredmény a Hangakadémia®, a Himalájai Hangtálmasszázs® Csúsztatásos technika®-jával kifejlesztett metodika alapján mutatható ki. Megfelelő mennyiségű, minőségű és bemért frekvenciájú hangtálakkal.